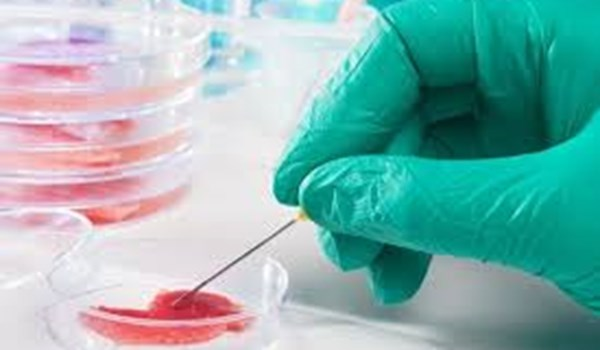
Cell Separation Technologies Market'

Caption: Cell Separation Technologies Market (Technology - Immunomagnetic Cell Separation, Fluorescence-activated Cell Sorting, Microfluidic Cell Separation, and Other Technology; Application - Stem Cell Research, Immunology, Cancer Research, and Other Applic
Credit: Infinium Global Research